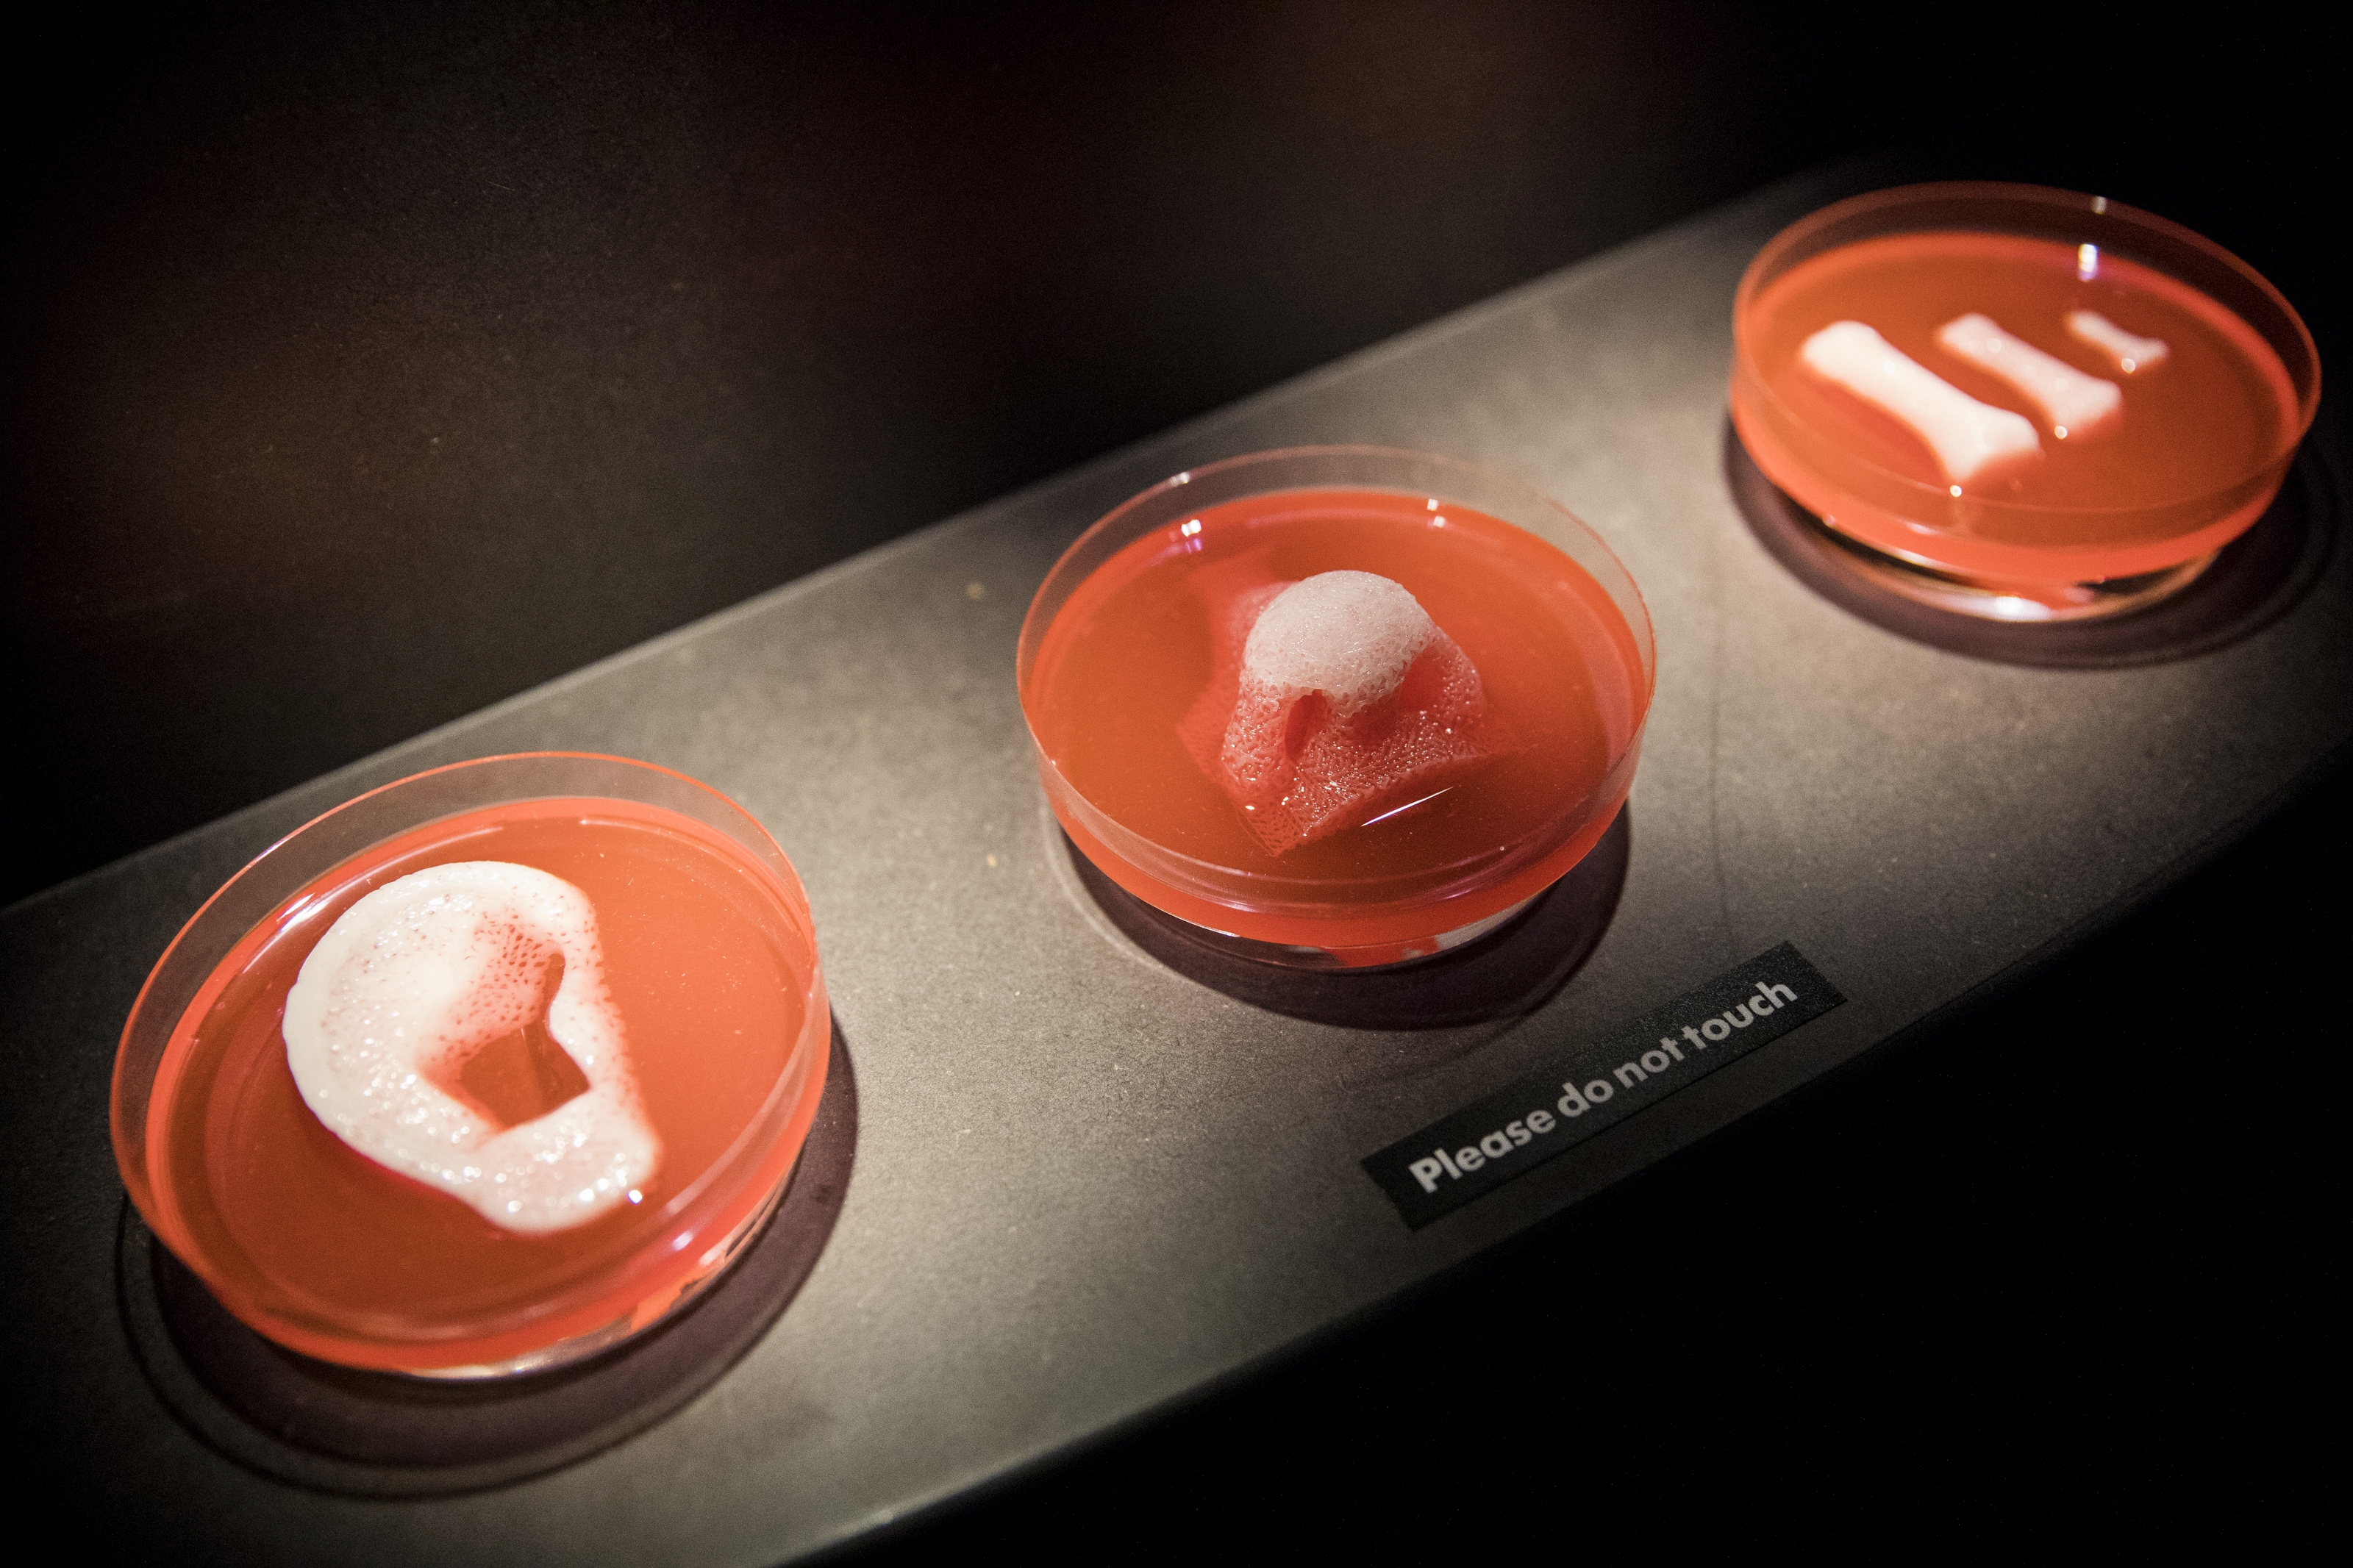

-
- container colonna1
- Categorie
- #iorestoacasa
- Agenda
- Archeologia
- Architettura
- Arte antica
- Arte contemporanea
- Arte moderna
- Arti performative
- Attualità
- Bandi e concorsi
- Beni culturali
- Cinema
- Contest
- Danza
- Design
- Diritto
- Eventi
- Fiere e manifestazioni
- Film e serie tv
- Formazione
- Fotografia
- Libri ed editoria
- Mercato
- MIC Ministero della Cultura
- Moda
- Musei
- Musica
- Opening
- Personaggi
- Politica e opinioni
- Street Art
- Teatro
- Viaggi
- Categorie
- container colonna2
- container colonna1
Storia e futuro delle intelligenze artificiali in mostra al Centro di Cultura Contemporanea di Barcellona
Progetti e iniziative
Dai dibattiti etici sulle armi automatizzate alle nuove ChatBot introdotte da Meta che permettono di conversare con le sorelle Kardashian, lo spettro in cui si muovono i dibattiti sull’utilizzo delle intelligenze artificiali spaziano tra allarmismo e il suo esatto opposto: un’indifferenza intrisa di post-ironia che non intende analizzare il mezzo ma solo assistere ai suoi traguardi e grotteschi fallimenti. Mai come in questo caso, però, un giudizio binario è poco utile o del tutto controproducente. L’utilizzo delle IA è modulato infatti da una zona di pensiero totalmente grigia, che ha a che fare – più di tutto – con il confronto tra la mente umana e il sempre più estraniante distacco dalle sue protesi esterne.
A offrire un quadro completo della storia, dei pensieri e degli esperimenti sull’argomento, la mostra AI: Artificial Intelligence inaugurata il 17 ottobre 2023 presso il CCCB – Centro di Cultura Contemporanea di Barcellona, dove rimarrà visitabile fino al 17 marzo 2024. A partire dal progetto espositivo AI: More Than Human inaugurato nel maggio 2019 al Barbican Centre di Londra, il CCCB ripropone i passaggi più significativi dell’evoluzione delle intelligenze artificiali, presentando allo spettatore un vero walkthrough nella storia (divisa in numerose Age d’or ed ere specifiche) della fascinazione umana verso la possibilità di dar vita a entità non-umane.

Il progetto espositivo, a cura del ricercatore Lluìs Nacenta e con la supervisione del Barcelona Supercomputing Centre, è infatti un viaggio attraverso le perversioni etiche dell’era tecnologica ma soprattutto un racconto dell’ossessione umana di donare al mondo artificiale caratteristiche naturali, e trova dunque la sua riuscita nel tracciamento di un percorso circolare che si ricolleghi all’alchimia e alle civiltà antiche prima di lanciarsi a capofitto dentro gli interrogativi futuri.


Tra i focus più rilevanti della mostra, una sezione sull’archetipo del golem in quanto materia informe resa senziente con la magia; sculture che provano la costruzione di nuovi ecosistemi artificiali che imitino quelli naturali (a cura del gruppo The Mediated Matter); la riflessione sui concetti di privato-pubblico dell’artista Lauren Mccarthy trasformatasi in una AI domestica à la Alexa; gli esperimenti sulle reti generative avversarie di Memo Akten; i contributi di pensatori contemporanei come Eryk Salvaggio e Takashi Ikegami; gli interventi di artisti come Steve Goodman (Kode9) e i Massive Attack, che hanno scelto di imprimere in stringhe di DNA sintetico il loro acclamato album Mezzanine.


Il percorso espositivo è articolato in quattro sezioni: Data Worlds, che riflette perlopiù su stereotipi e bias promossi dalle grandi banche di dati da cui le IA generative attingono; Mind Machines, rivolta al machine learning e alle modalità in cui le macchine acquisiscono una vera e propria intelligenza che emuli quella umana; The Dream of AI, che in modo sorprendente racconta il desiderio antico (e magico) di creare intelligenze autonome passando per il giudaismo e lo shintoismo; Endless Transformation, che interroga lo spettatore sul futuro delle IA e sulla loro stessa ontologia, cercando di suscitare un pensiero critico che possa allontanarsi dal binarismo buono-cattivo.

Curare un progetto che esponga i visitatori al quadro completo di un argomento così scisso, complesso e spesso dispersivo è un’impresa che prevede grande lavoro storiografico e la presentazione di una molteplicità di opinioni, che il CCCB supporterà tramite talk, dibattiti, performance e masterclass laterali con personaggi dal calibro di N. Katherine Hayles – tra le più rilevanti pensatrici contemporanee – e artisti da background differenti (musica, performance, arti figurative).


Doloroso, tuttavia, l’eco lontano di The Influencers, il festival curato da Eva e Franco Mattes e Bani Brusadin dal 2004 al 2019 proprio al CCCB, dedicato alle più interessanti intersezioni di arte e media digitali e a temi quali user culture, social media realism, hacktivismo e Net-Art. Dalla lucidissima capacità di analisi del mondo contemporaneo e con la partecipazione di personalità come Ai Weiwei, Olia Lialina, Kenneth Goldsmith, James Bridle e Franco Bifo Berardi, il festival cui ultima edizione risale ormai a quattro anni fa conserva oggi la stessa – se non una maggiore – urgenza: la necessità di approfondire ulteriormente i legami tra tecnologia e humanities, che mostre dall’impianto decisamente più scientifico come quella curata da Lluìs Nacenta riescono a suggerire solo in una cornice più generica e decisamente più schematica.




























EUROVISION XXXVI è RITORNATA A VILLA MEDICI
30/31.10.2023
le sfide poste dall’Intelligenza Artificiale nel settore audiovisivo e alla proprietà intellettuale necessitano di regolamenti
sia nel pubblico che nel privato, incluso Vloggers and Influencers
l’EUROPA unita guarda al Futuro e difende la creatività ARTISTICA nei MEDIA